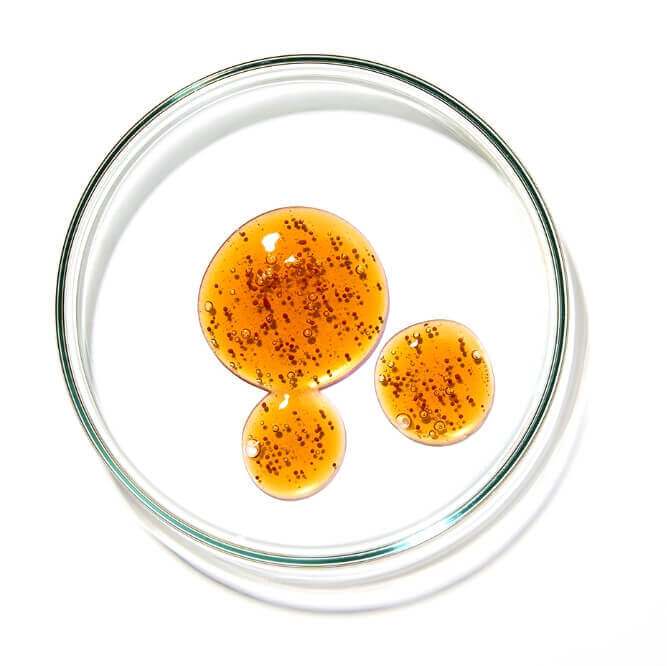

毎日のお手入れを、もっとシンプルに、
もっと確かなものへ。
肌・からだ・心に寄り添い、
効果を実感できる美容体験をお届けします。
落とす、与える、実感する。
今日のケアが、
未来の美しさをつくる。
LINE UP
*1 アスタキサンチン(整肌成分) , 純粋レチノール/レチノール(整肌成分) , セラミド/セラミドNP、セラミドNG、セラミドAP(保湿、皮膚の保護成分) , ビタミンA誘導体/パルミチン酸レチノール(保湿、整肌成分) , ビタミンE誘導体/酢酸トコフェロール(整肌成分) , グリセリン(保湿、皮膚の保護成分) , ビタミンC誘導体/リン酸アスコルビルMg(整肌成分)
VOICE

※CC1を体験いただいた人の声をピックアップして掲載してています。
※モニターステーション引用


長年培ってきた配合技術を生かし、
確かな品質の製造・管理のもと開発された
CC1の開発ストーリー
STORY

OFFICIAL
LINE ACCOUNT
公式LINE
LINE限定クーポンやお得情報を配信中


































































